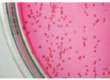
Laboklin: Bordetella bronchiseptica – Reinkultur auf Selektivnährboden

Fast täglich wird in den Medien über neue Nachrichten zu nosokomialen Infektionen berichtet. Zwar werden diese häufiger in Zusammenhang mit humanmedizinischen Problemstellungen dargestellt, jedoch sollte die Thematik auch in der Tiermedizin nicht unbeachtet bleiben. Durch den erleichterten Zugang zu Informationen durch das Internet werden von Tag zu Tag sowohl Tierärztinnen und Tierärzte als auch Tierbesitzer für das Thema sensibler.
Nosokomiale Infektionen sind Infektionen, welche der Patient vor Aufnahme in die Klinik oder Praxis nicht hatte. Das Tier befand sich auch nicht in der Inkubationszeit. In der tierärztlichen Klinik können auf stationär behandelte Tiere pathogene und fakultativ pathogene Mikroorganismen übertragen werden, die zu einer nosokomialen Infektion führen. In der Regel sind diese postoperative Wundinfektionen, Harnwegsinfektionen (z.B. nach Anwendung eines Harnkatheters) oder Infektionen nach einer endoskopischen Untersuchung. Mit einer effizienten Reinigung und Desinfektion kann die Gefahr der Übertragung auf andere Tiere nahezu verhindert werden. Postoperative Wundinfektionen führen zu mehr als 50% der Folgekosten aller nosokomialen Infektionen und sind somit auch von volkswirtschaftlichem Interesse. Mit einfachen hygienischen Maßnahmen kann die Gefahr einer möglichen „never ending story“ abgewendet und die Qualität der Dienstleistungen in der tiermedizinischen Praxis verbessert werden.
Durch die Entwicklungen der letzten Jahrzehnte wurden humanmedizinische diagnostische Methoden wie Endoskopie und Katheterisierung für die Tiermedizin übernommen, wodurch sich mehr Eintrittspforten für nosokomiale Infektionen ergeben haben. Unterschiedliche Studien belegen, dass Kontaminationsgrade von chirurgischen Wunden in der Veterinärmedizin weitaus über dem Anteil liegen, die aus der Humanmedizin bekannt sind. Die häufigsten nosokomialen Infektionen gehen von fakultativ pathogenen Keimen aus, die zur normalen Flora des Menschen oder der Tiere gehören. Die wichtigsten Erreger sind unter anderem Escherichia coli, Staphylococcus aureus, Staphylococcus pseudintermedius, Pseudomans aeruginosa, Klebsiella sp., Pasteurella multocida, Candida albicans und ähnliche. In diesem Zusammenhang darf nicht außer Acht gelassen werden, dass eine nosokomiale Infektion in der Tierarztpraxis durch die Übertragung von Mensch zu Mensch, Tier zu Tier aber auch Mensch zu Tier zustande kommen kann.
Hygienekonzept für die Tierarztpraxis
Aufgrund der oben aufgeführten Problematik ist ein Hygienekonzept für die Tierklinik oder Praxis dringend anzuraten. Die Basis für die Erstellung eines Hygienekonzeptes bilden die Unfallverhütungsvorschriften BGV C8, die Gefahrstoff-VO, die Desinfektionsmittellisten sowie die Biostoffverordnung. Die Maßnahmen, die der Gesetzgeber bislang für die praktizierenden Tierärzte vorgeschrieben hat, stellen nur die Mindestanforderungen an ein Hygienekonzept dar und sind eher auf den Schutz des Menschen in der Praxis ausgelegt. Dabei sollte einer der Gründe für ein Hygienekonzept in der Tierarztpraxis die Vermeidung von nosokomialen Infektionen sowohl beim Menschen als auch beim Tier sein. Dieses Vorgehen würde dem Tierarzt eine erhöhte Rechtssicherheit geben. Der Tierarzt hat die Möglichkeit, durch eine effiziente Dokumentation nachzuweisen, dass er nach dem neuestem Stand der Wissenschaft arbeitet. Letztlich dient ein solches Konzept der Sicherung eines höheren Qualitätsstandards und als Instrument, mit welchem sich Praxen voneinander qualitativ unterscheiden können. Dies erfordert ein verbindliches Hygienekonzept für alle Mitarbeiter. Zunächst einmal müssen hierfür die jeweiligen Hygieneregeln festgelegt werden. In diesem Zusammenhang ist es sinnvoll einen freiwilligen Mitarbeiter ein Hygieneseminar besuchen zu lassen, wonach dieser als Hygienebeauftragter ernannt wird. Nach der Hygieneschulung werden die kritischen Punkte und Abläufe der Praxis bzw. Klinik ermittelt. Bei der Erstellung eines Hygieneplans muss darauf geachtet werden, das jeder Mitarbeiter die entsprechenden Maßnahmen nachvollziehen und anwenden kann. Dazu ist es wichtig alle relevanten hygienischen Tätigkeiten tabellarisch in einem Hygieneplan so darzustellen, dass die Fragen WAS?, WO?, WANN?, WOMIT?, WER? beantwortet werden können. Spezielle Anweisungen für medizinische Geräte sowie Ansprechpartner für wichtige Fragen müssen aus dem Hygieneplan ersichtlich sein. Dann kann ein Probelauf gestartet werden, wonach nochmals alle Änderungsvorschläge der Mitarbeiter berücksichtigt und ein Hygienekonzept endgültig formuliert wird.
Beispielsweise sollten je nach Praxis oder Klinik folgende Punkte im Hygieneplan dargestellt werden:
- Die Pflicht, Abeitskleidung zu tragen (je nach Arbeitsbereich Kittel, Mundschutz, Handschuhe usw.)
- Das Ablegen von Schmuck während einer Tätigkeit (z. B. OP)
- Handhygiene (keine langen Fingernägel, Reinigung und Desinfektion)
- Handpflege (Wunden bergen ein Infektionsrisiko)
- Operationen/Behandlungen (Patienten und Mitarbeiterschutz, Reihenfolge der OP‘s je nach Kontaminationsgrad)
- Flächen- und Raumdesinfektion
- Reinigung und Desinfektion von Geräten und Instrumenten
- Spezielle Anweisungen für medizinische Geräte (optional)
- Ansprechpartner bei Fragen
Überprüfung der Hygienemaßnahmen
Zu einem Hygienekonzept gehört auch die kontinuierliche Überprüfung der angewandten Maßnahmen. Dabei ist die Dokumentation dieser wichtig, damit die tierärztliche Praxis im Falle eines Rechtstreits nachweisen kann, dass sie nach neuestem wissenschaftlichen Stand gehandelt hat.
Für die Humanmedizin sind solche Überprüfungen u. a. nach dem Infektionsschutzgesetz vorgeschrieben, ebenso wie die Dokumentation von Patienten mit einer nosokomialen Infektion. Der veterinärmedizinischen Praxis hingegen werden solche Untersuchungen bislang nur empfohlen. Die auch für Tierarztpraxen gültige Biostoff-VO schreibt in §11 jedoch vor, die technischen Schutzmaßnahmen regelmäßig zu überprüfen, ohne dies jedoch näher zu spezifizieren. Dies bedeutet für die Tierklinik die Überprüfung sämtlicher Hygienemaßnahmen sowie die Wartung und Pflege der jeweiligen Geräte und Instrumente nach Herstellerangaben.
Zur Überprüfung der Reinigungs- und Desinfektionsmaßnahmen in der Tierklinik können folgende Kontrollen im Abstand von 6 Monaten (2x jährlich) durchgeführt werden:
- Die Kontrolle der Heißluftsterilisatoren bzw. Dampfsterilisatoren (Autoklav) mittels Bioindikatoren.
Die Leistung des Sterilisators wird anhand von 5 Bioindikatoren überprüft. Dabei ist es wichtig die Bioindikatoren im Sterilisator an verschiedenen Stellen so zu platzieren, dass möglichst eine repräsentative Überprüfung des Gerätes möglich ist. Wird die Leistung des Sterilisators bei zwei Überprüfungen nicht beanstandet, kann eine Zertifikat über die erfolgreiche Überprüfung der Sterilisation ausgestellt werden. - Die Kontrolle der Endoskopdesinfektion: Die Kontrolle der Endoskopdesinfektion sollte besonders Beachtung finden, da das Endoskop eine mögliche Eintrittspforte für nosokomiale Infektionen darstellen kann. Die Überprüfung erfolgt anhand von Spülprobe aus dem distalen Spülkanal sowie des Luft-Wasser-Kanals. Zusätzlich werden Abklatschproben vom distalen Ende des Endoskops und vom Luft-Wasser-Kanal entnommen.
- Die Kontrolle der Reinigungs- und Desinfektionsmaßnahmen von verschiedenen Oberflächen: Dabei werden wie üblich die zu beprobenden Oberflächen gereinigt und desinfiziert. Anschließend erfolgt die Beprobung der Oberflächen mittels Abklatschplatten. Auch für die Überprüfung der Reinigungs- und Desinfektionsmaßnahmen kann auf Wunsch ein Zertifikat erstellt werden.
Mögliche zu beprobende Oberflächen sind:
– OP- oder Behandlungstische
– OP-Lampengriff
– Tastatur
– Türgriff u. ä. - Kontrolle der Desinfektionsleistung von Instrumentenspülmaschinen
Sofern diese Geräte in der Veterinärmedizin zum Einsatz kommen, ist eine Überprüfung der Desinfektionsleistung möglich.
Möchten Sie die Reinigungs- und Desinfektionsmaßnahmen in Ihrer Tierarztpraxis überprüfen, so können Sie alle hierfür notwendigen Materialien, zusammen mit einer detaillierten Anwendungsbeschreibung, über uns bestellen. Wir informieren Sie auch gerne telefonisch über den jeweiligen Untersuchungsgang.
EIN TIPP, bei Kontrollen in Ihrer Tierarztpraxis sollte:
- Hygieneplan in Kurzform aushängen
- Alle Gefahrenstoffe in einem Verzeichnis dokumentiert sein
- Vorhandene Sicherheitsdatenblätter abgeheftet werden
- Betriebsanweisungen aushängen
- Mitarbeiterunterweisung dokumentiert sein
- Gefährdungsbeurteilung erstellt werden
- Entsprechende Vordrucke und Formulare können Sie auch bei der BGW anfordern.
06 / 2012